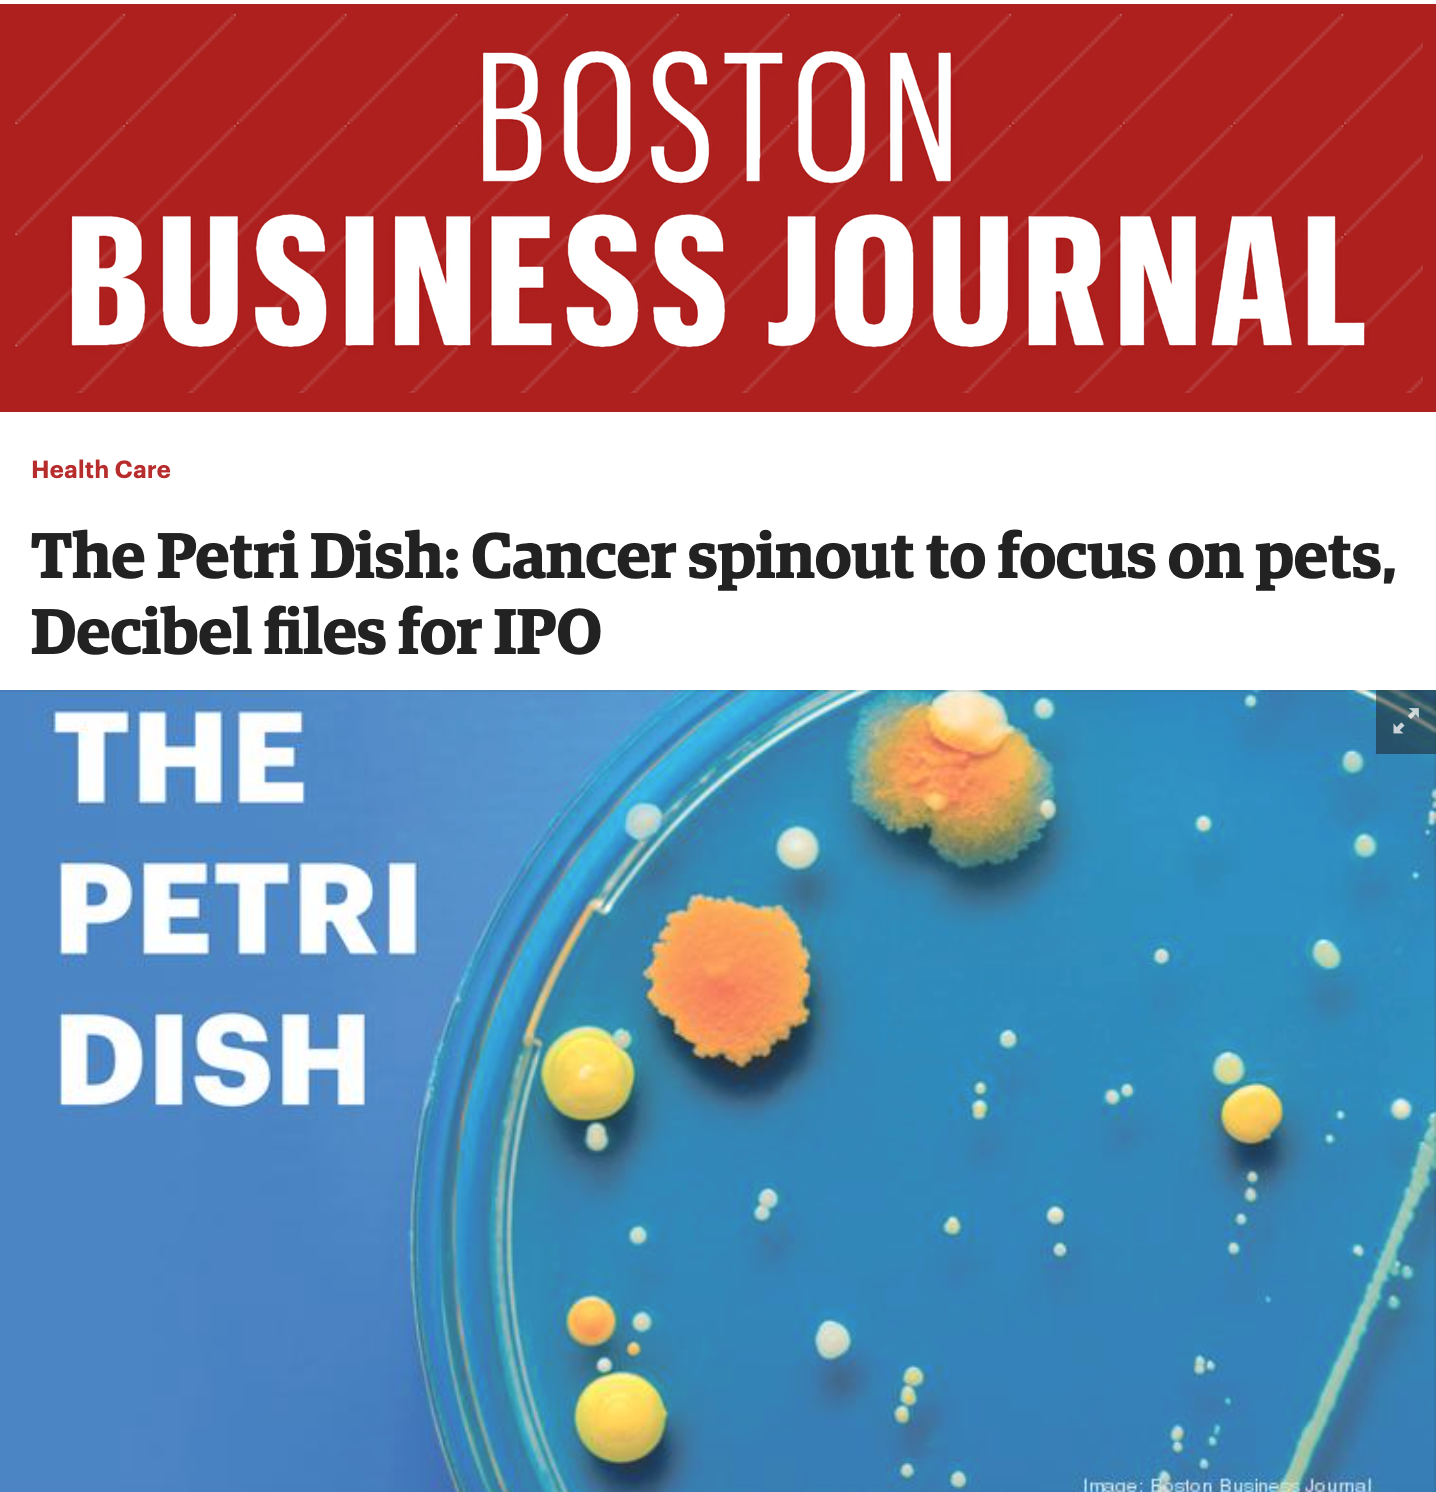

CureLab Oncology forms veterinary oncology subsidiary to fight pet cancer
Vet-focused subsidiary joins the fight against cancer and inflammation-related diseases in pets
The goal is to bring to market a new therapy that will be based in CureLab Oncology's Elenagen gene therapy. ElenaVet® enhances the body's anticancer immune response. CureLab Veterinary has already conducted some comparative medicine studies, in which ElenaVet saved 10 out of 11 dogs with breast cancer and precluded or delayed the metastatic process in dogs with melanoma. Similar results were observed with cats.
ElenaVet also reduces chronic inflammation, which causes not only cancer but other serious diseases such as osteoarthritis, Inflammatory bowel disease (IBD), and chronic dermatologic issues — as well as age-associated declines. The team's goal is to tackle these diseases one by one, starting with cancer.
Coverage secured in both local business and vet media
CureLab Oncology Launches Veterinary Oncology Subsidiary, CureLab Veterinary
Based on a scientifically solid proof of concept in dogs and cats, an international IP portfolio, and a comprehensive scientific advisory board that includes key opinion leaders and experienced management, CureLab Veterinary intends to raise initial financing through a crowdfunding campaign set to launch within a month, and to become profitable within 36 months of raising funds.
BOSTON – January 21, 2021: CureLab Oncology, a clinical-stage pre-IPO biotech company, has launched CureLab Veterinary, a subsidiary with exclusive worldwide rights to apply CureLab Oncology patents to treat dogs, cats and horses. The first target market for CureLab Veterinary’s patented DNA therapeutics will be to treat cancer in dogs and cats.
Cancer is the primary cause of death for dogs in the United States, and in Europe canine cancer incidence is even higher because fewer dogs are neutered. In published studies, CureLab Veterinary successfully treated breast cancer in 10 out of 11 dogs using the company’s DNA therapeutic. CureLab Veterinary plans to publish data that indicates its products will be effective against cancers in cats as well as other types of canine cancer such as melanoma.
“Cancer and osteoarthritis have a common contributing factor, chronic inflammation. Thus, our second target will be osteoarthritis affecting 70 percent of older dogs and 100 percent of older cats,” said Alex Shneider, Ph.D., CEO of CureLab Oncology, and founder and chairman of CureLab Veterinary.
The CureLab Veterinary team is supported by Robert Devlin, DVM, MBA, who has more than 25 years of successful US and international clinical and business experience in R&D and marketing of veterinary therapeutic products and will direct the approval process for CureLab Veterinary’s therapies, which will focus on the United States Department of Agriculture Center for Veterinary Biologics (USDA-CVB).
“Receiving market authorization through the USDA approval process is cost efficient and relatively fast. FDA and USDA officials have reviewed CureLab Veterinary’s file and have stated we should proceed through the USDA approval process. The first meeting with USDA officials was very encouraging,” said Devlin.
To streamline the regulatory process, the company has engaged consultants with many years of experience with the USDA. CureLab Veterinary has also formed a comprehensive scientific advisory board of key opinion leaders in veterinary medicine with successful academic and private industry track records. These advisors include oncologists, gastroenterologists, orthopedists, dermatologists, and other veterinary professionals.
Currently, the company is interviewing and evaluating contract manufacturers to produce its product and assist CureLab through the approval process and market introduction.
CureLab Veterinary intends to raise initial financing through a crowdfunding campaign, set to launch within a month. The company expects to be profitable within three years.
About Elenagen and ElenaVet
CureLab Oncology’s lead product, Elenagen, is a DNA-encoding gene called p62/SQSTM1. Elenagen reverses tumor grade, changes tumor microenvironment, enhances the anti-cancer effects of other therapies (such as chemotherapy), mitigates chronic inflammation, and stimulates an immune attack on the tumor. For the veterinary market, CureLab Veterinary will market the therapy as ElenaVet®, an Elenagen derivative. To learn more, visit curelabveterinary.com .
About CureLab Oncology
CureLab Oncology Inc. is a clinical-stage immuno-oncology biotech company headquartered in the greater Boston area. CureLab is dedicated to advancing new and safer therapeutics for solid tumors and other oncology and inflammatory indications. To learn more, visit curelab.com.